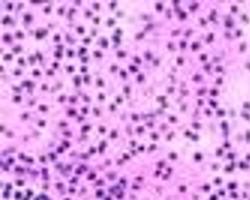

剥脱性皮炎型药疹
病理病因
 大多数都具有引起药疹的性,其中包括中草,但以抗原性较强者引起的最多。多为鲁米那,磺胺类,保泰松,苯妥英钠,对氨基苯甲酸,链霉素,金、砷等重金属。如羟吡唑嘧啶、甲氧噻吩头孢菌素、甲氰咪胍、氯喹、异烟肼、硫酰脲等亦可引起。此外,对患有先天过敏性疾病的机体及器官患有疾病的,发生药疹的性大。
大多数都具有引起药疹的性,其中包括中草,但以抗原性较强者引起的最多。多为鲁米那,磺胺类,保泰松,苯妥英钠,对氨基苯甲酸,链霉素,金、砷等重金属。如羟吡唑嘧啶、甲氧噻吩头孢菌素、甲氰咪胍、氯喹、异烟肼、硫酰脲等亦可引起。此外,对患有先天过敏性疾病的机体及器官患有疾病的,发生药疹的性大。
临床表现
多由常由磺胺类,巴比妥类,抗癫痫药(如苯妥英钠,卡马西平等)解热镇痛类,抗生素等药引起,此型药疹多是长期用药后发生,首次发病者潜伏期约20日,有的病例是在麻疹样,猩红热样或湿疹型药疹的基础上,用药或不当所致,皮损初呈麻疹样或猩红热样,逐渐,融合成全身的弥漫性潮红,肿胀,尤以面部及手足为重,可有丘疱疹或水疱,伴糜烂,少量渗出,2-3周,皮肤红肿渐消退,全身出现鳞片状或落叶状脱屑,手足部则呈手套或袜套状剥脱,头发,指(趾)甲可脱落,病愈后再生,口唇和口腔粘膜红肿,或出现水疱,糜烂,疼痛而进食,眼结膜充血,水肿,畏光,分泌物增多,重时可发生角膜溃疡,全身浅淋巴结常肿大,可伴有支气管肺炎,性肝炎,外周血细胞可提高或降低,甚至出现粒细胞缺乏 。
检查诊断
治疗措施
附件列表
词条内容仅供参考,如果您需要解决具体问题
(尤其在法律、医学等领域),建议您咨询相关领域专业人士。
剥
剥